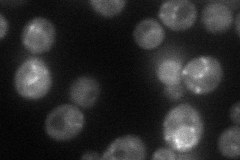
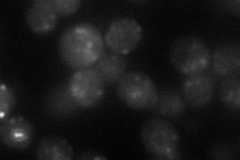
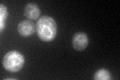
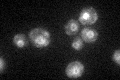

View description
Dihydrosphingosine phosphate lyase, regulates intracellular levels of sphingolipid long-chain base phosphates (LCBPs), degrades phosphorylated long chain bases, prefers C16 dihydrosphingosine-l-phosphate as a substrate
Localization:
Intensity:
Fold change:
Significance:
-
C’ GFP library in SD

ER44.06 -
N' NOP1pr-GFP in SD
punctate44.5841 -
N' TEF2pr-mCherry in SD
punctate34.9326 -
N' NATIVEpr-GFP in SD

below threshold23.6 -
N' TEF2pr-VC and Cyto-VN in SD

below threshold25.2892 -
C’ GFP library in SD+DTT
ER55.691.26No -
C’ GFP library in SD+H2O2

ER59.691.35Yes -
C’ GFP library in Starvation Media
ER45.51.03No -
C’ GFP library on the background of Pup2-DaMP

ER -
C’ GFP library on the background of CCT mutant

ER59.83471.35786Yes
